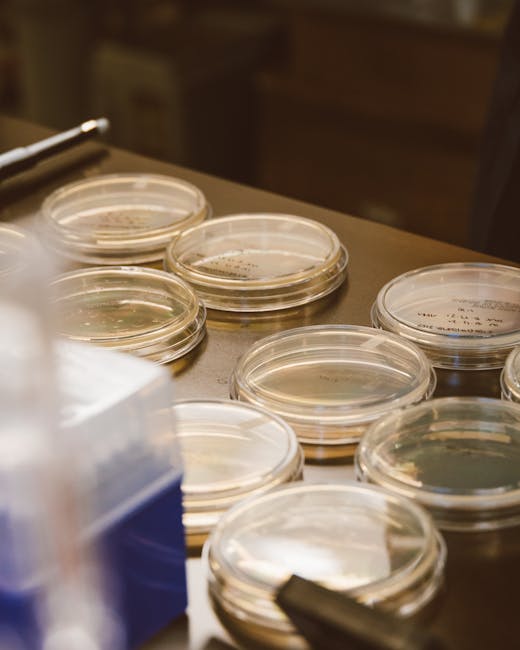

The Promise and Perils of CRISPR-Cas9
The Technical Marvel of CRISPR-Cas9: A Bacterial Defense Repurposed The core of the CRISPR-Cas9 system is derived from a naturally occurring immune mechanism in bacteria. When a virus, known as a bacteriophage, infects a bacterium, the bacterium captures snippets of the virus’s genetic material and incorporates them into its own genome in specialized regions called …